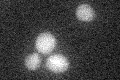
YHR047C
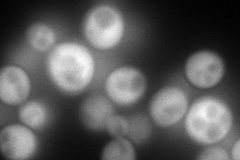
YHR047C
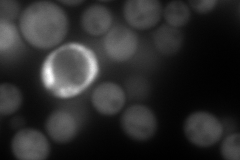
YHR047C
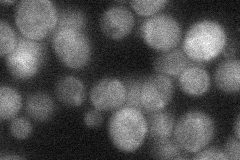
YHR047C
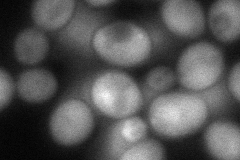
YHR047C
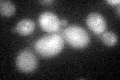
YHR047C

View description
Arginine/alanine aminopeptidase, overproduction stimulates glycogen accumulation
Localization:
Intensity:
Fold change:
Significance:
-
C’ GFP library in SD
below threshold14.82 -
N' NOP1pr-GFP in SD
cytosol210.274 -
N' TEF2pr-mCherry in SD
cytosol291.165 -
N' NATIVEpr-GFP in SD
cytosol26.6639 -
N' TEF2pr-VC and Cyto-VN in SD
cytosol80.7376 -
C’ GFP library in SD+DTT
cytosol17.991.21No -
C’ GFP library in SD+H2O2

cytosol14.20.95No -
C’ GFP library in Starvation Media

cytosol15.891.07No -
C’ GFP library on the background of Pup2-DaMP

below threshold -
C’ GFP library on the background of CCT mutant

below threshold15.52781.04737No
